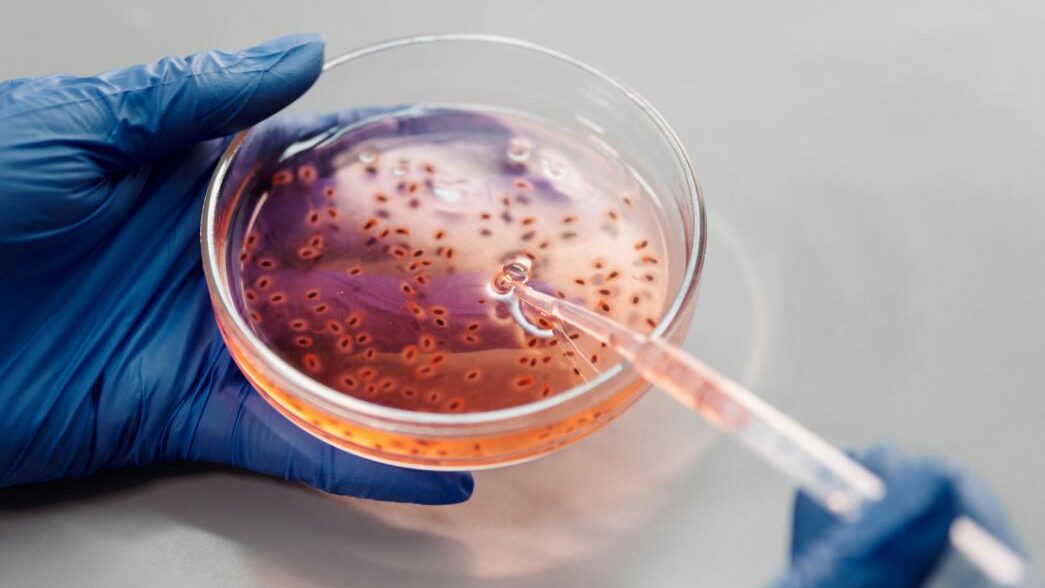
Gloved hands holding a petri dish with liquid and pipette.

Transgender Sports and the Athletes
Since time immemorial, sports have been part of the global culture. Most people participate in sports as a hobby while some, for professional reasons. In most sporting activities, competition exists. Along with this competition are winners, runner-ups, and various placements.
This is why when trans people started to reclaim their basic human rights, the talk of trans in sports and transgender athletes became controversial. However, one must understand that even if sports aim to promote discipline and sportsmanship, entertain, and improve lives, certain traditions are not meshing well with inclusivity.
On this page
Gender Differences in Sports
Because you already know the fundamentals of sports, it’s time to discuss certain distinctions. Traditionally, competitive sports and sporting events have imposed a dichotomy. This is the separation of competitions based on genders.
Naturally, most males are stronger than females physically. This is why to incorporate fairness in competitions, males have been separated from females. There’s:

This is why when transgender people, most especially trans women started regaining their basic human rights, the sector of sports has been affected. Many people disagree with transgender women competing in female sports.
They say that cisgender women are disadvantaged because trans women are naturally stronger and faster. While it’s a valid argument, it also cemented the exclusion of trans women from national sporting competitions.
Transgender and Sports and Transgender Athletes
Because the debates of including transgender women in women’s sports lead towards the topic of hormones and physical strength, certain compromises have been observed.
To incorporate fairness, some sporting events check the hormone levels of transgender women before the games begin. If their hormones are in the female range, the organizers allow transgender women to compete against cisgender women.

However, not all sporting event organizers are open to this kind of idea. Added to that, the majority of sports fans just don’t find this setup fair for cisgender women.
Currently, in 2021, no standards have been set yet for allowing trans women to join women’s sporting events. There have also been no strides upon creating trans sports exclusive to trans people yet. But that’s not to say that transgender athletes don’t exist yet.
2021 Transgender Sports Update
Just this year, a silver lining was witnessed when President Joe Biden took the seat. He rolled out an executive order to include all transgender female athletes in sporting events.
The said Executive Order aims to Preventing and Combating Discrimination on the Basis of Gender Identity or Sexual Orientation. It was signed on his inauguration day. One of the orders is for the educational institutions that receive funding from the government, is to allow individuals who identify as women to join women’s sports teams in school.
However, this was not music to the ears of certain high-profile women. These are well-known women’s sports leaders, including Martina Navratilova who is a multiple Olympian and a tennis legend.
Scientific Approach in Including Transgender Women into Women’s Sports
But this does not mean that they are protesting against the executive order in a baseless manner. Nancy Hogshead-Makar, an attorney and one of the leaders of the Women’s Sports Policy Working Group appealed.
“We fully support the Biden executive order, ending LGBT discrimination throughout society, including employment, banking, family law and public accommodations–Competitive sports, however, are akin to pregnancy and medical testing; these areas require a science-based approach to trans inclusion. Our aim has been on protecting the girls’ and women’s competitive categories, while crafting accommodations for trans athletes into sport wherever possible.”
International Olympic Committee’s Stand on Trans Athletes
As of today, IOC’s (International Olympic Committee) policy, which was decided back in 2015, states that trans women can compete in women’s sports if they’re suppressing their testosterone levels for 12 months by using medication.
Today, they’re thinking of changing the policy to include all female athletes to match a certain testosterone level.
High School Sports for Athletic Transgender Youth
There are many debates on whether or not trans teens could join female sports in high schools.
Many believe that trans girls have an unfair advantage compared to cis girls while one retired high school coach says otherwise.
According to Larry Strauss, an English teacher and retired basketball coach in South Los Angeles:
“In real life, transgender girls in sports are a non-controversy-We belatedly stopped excluding athletes of color from high school and college sports. How many more years will people try to exclude trans athletes?”
What Joe Biden’s Presidency means for Trans Athletes
Although Joe Biden’s goal of inclusivity is noble, certain protocols must be observed before they get signed into law. Sports are highly competitive and winners should be announced based on:
- fairness
- merits
- and hard work

Currently, everything is fuzzy about his executive order. Just like what Hogshead-Makar added,
“While the details of President Biden’s executive order remain fuzzy, asking women — no, requiring them — to give up their hard-won rights to compete and be recognized in elite sport, with equal opportunities, scholarships, prize money, publicity, honor and respect, does the cause of transgender inclusion no favors–”
She added by saying,
“–It engenders justifiable resentment, setting back the cause of equality throughout society. And either extreme position – full inclusion or full exclusion in sport – will make life much harder for transgender people. We must make sport a welcoming place for all.”
Famous Transgender Athletes
Amidst all of the confusion and murky waters, trans athletes still exist. Some of them are even Olympians.
Caitlyn Jenner
She is probably if not the most popular transgender athlete of all time, one of the most. However, she did not get her Olympic gold medals after transitioning. She got her first Olympic success in 1974. Her first win was in a men’s decathlon event the same year.
She also won 1st place in the Pan American Games and Olympic Games in 1974 and 1975 accordingly.
Because of the fame that she gained from being a successful decathlon, she became a spokesperson for the breakfast cereal brand Wheaties in the 70s. She has also appeared in various TV and movie shows in the same era.

Nowadays, she’s most famous for controversially coming out as a transgender woman. She did so while still shooting Keeping up with the Kardashians and being known as the patriarch of the family.
Many reactions were negative but it was an impactful stride for the transgender community. Because of the tantamount audience of the reality TV show, her story was able to reach impressive numbers. Her courage opened the eyes of many people to educate themselves on what transgenderism is.
Follow Caitlyn Jenner: Facebook | Instagram | Youtube | IMDb
Chris Mosier
Mosier started his athletic career before transitioning to a man. In 2015, he was able to take a spot on the Team USA sprint duathlon men’s team for the World Championship in 2016. He became well-known after being the first openly transgender athlete member in a U.S. national team.

His professional strides did not only stop at his own career. He is also the founder of transathlete.com. The website is a resource for trans athletes, coaches, students, and administrators to discover updates about trans-inclusion in the sports world.
He’s also working with different sports organizations to strengthen the inclusion of trans athletes in the sports world. In 2020, Mosier competed in the US Olympic Team Trials for the 50k Racewalk event. He did not get placement because he was injured during the race.
Follow Chris Mosier: Facebook | Instagram | Threads | Youtube | TikTok | Official Website
Lia Thomas
She’s probably one of the most controversial transgender athletes of today. Lia Catherine Thomas, the first openly transgender athlete who won in an NCAA I national championship, sparked many conversations about transgender women in sports.

Thomas won the women’s 500-yard freestyle event and this was what made a lot of people question if her win was just. Fox news, including several religious media, covered the issue about anonymous parents of swim team members of University of Pennsylvania’s asking the institution to declare her, ineligible to compete.
Brooke Forde, an Olympic silver medalist, said of Thomas that,
I believe that treating people with respect and dignity is more important than any trophy or record will ever be, which is why I will not have a problem racing against Lia at NCAAs this year.
Another swimmer, Olympic silver medalist Erica Sullivan, supported Thomas in an opinion piece for Newsweek by saying,
like anyone else in this sport, Lia has trained diligently to get to where she is and has followed all of the rules and guidelines put before her… she doesn’t win every time. And when she does, she deserves, like anyone else in this sport, to be celebrated for her hard-won success, not labeled a cheater simply because of her identity.
Follow Lia Thomas: Instagram
Renee Richards
Unlike Jenner, Richards was able to win sporting events while competing against cisgender women. She is an ophthalmologist and a former tennis player. Her athletic career brought upon success in the 70s professional sporting circuit.
She is best known for fighting to be able to compete in the US Open in 1976 after undergoing gender reassignment surgery.

She was outed as a trans woman by a local TV anchor named Richard Carlson in 1976. Because of this:
- The United States Tennis Association (USTA)
- The United States Open Committee (USOC)
- and The Women’s Tennis Association (WTA)
imposed female competitors to undergo a gender verification through chromosome testing.
Richards refused the test and was not allowed to compete in the Open, Wimbledon in 1976. Subsequently, she sued USTA for discrimination by gender in violation of the New York Human Rights Law. Because of this, she was allowed to play in the US Open in 1977.
The Future of Transgender Athletes
Some people say that there should be trans sports. However, that goes against the fight for inclusion that trans people deserve. Many talks and debates are happening now because both the anti and pros have very good points. The inclusion of trans athletes still has a long way to go.
If you want to open a healthy debate amongst your friends who are into world athletics, kindly share this article.